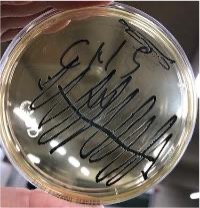
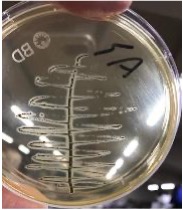

資源を循環させ、農業を強くする。低コスト・広域流通ペレット堆肥の実証
掲載日:2026.04.01
コーヒー粕の敷料利用。 産学官の知恵を繋ぎ、
未利用資源の牛舎敷料利用に挑む。持続可能な農業の新たなスタンダード。
〜自治体・畜産農家・関連企業×本学:ペレット堆肥広域流通実証プロジェクト〜
【この活動のポイント】
- 未利用資源のアップサイクル: コーヒー粕などを「代替敷料(牛のベッド)」として活用。廃棄物を価値ある資源へと転換する。
- 徹底した科学的検証: 病原菌の安全確認から、乳牛の行動観察、堆肥化後の植物生育試験まで。実用性と安全性を全方位から検証。
- 広域流通への挑戦: 扱いやすい「ペレット状」に加工。低コストな生産体系を確立し、地域を越えた資源循環システムの構築を目指す。
【活動紹介】
「捨てる」を「活かす」へ。農業の未来を救う資源循環
持続可能な農業の実現に向け、本学は自治体や畜産農家、企業と強力なタッグを組み、ペレット堆肥の広域流通に関連する研究として、敷料として利用可能な資材や生産コストの検討を行っています。その鍵を握るのが、コーヒー粕などの未利用資源の活用です。
牛の健康から植物の成長まで、一気通貫の検証
私たちは、コーヒー粕を代替敷料として活用するためのプロセスを科学的に検証しました。学外機関と協力し、安全性の確認(病原菌チェック)はもちろん、実際に牛舎へ導入した際の乳牛の行動やストレスを細かく観察。さらに、堆肥化された後の肥料が植物の生育にどう寄与するか、多角的な試験を実施しました。
産学官の連携が創る、低コスト・高付加価値モデル
検証の結果、この技術は実用性と安全性を兼ね備えた「資源循環型技術」として極めて有効であることが示されました。 酪農学園大学は、現場の農家と都市の企業、そして行政を繋ぐハブとなり、大地から生まれる資源を余すことなく活用する、新しい農業のカタチを提案し続けます。